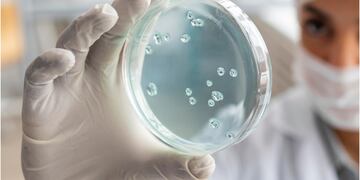
Virus. Imagen de referencia, Freepick.

perfil
KARD: La fusión del k-pop y el reggaeton que conquista el mundo
Debutados en 2017, el grupo mixto conformado por Somin, Jiwoo, BM y J.Seph logró conquistar la industria musical gracias a sus nuevos sonidos inspirados en el reggaeton y lo tropical. La fusión llamó la atención rápidamente de los fanáticos del K-pop, especialmente en Latinoamérica.